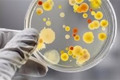

За минулий тиждень у Шосткинській громаді зареєстровано 4 випадки покусів тваринами. 1 дитина та 3 дорослих постраждали від укусів собак. Загалом за 4 місяці 2024 року кількість покусів сягнула 19, з яких 7 випадків (36,8%) припадають на безпритульних тварин.
У 2023 році за весь рік було зареєстровано 108 випадків, 42 з яких (38,8%) припадали на безпритульних тварин.
Покуси тваринами можуть нести серйозну загрозу для здоров'я людей, адже вони можуть призвести до інфікування такими небезпечними захворюваннями, як сказ, правець, лептоспіроз.
Якщо вас вкусила тварина, яка може бути заражена сказом:
- Негайно промийте рану водою з милом протягом 15 хвилин.
- Зверніться за медичною допомогою.
- Зберігайте тварину, яка вас вкусила, протягом 10 днів для спостереження за ознаками сказу.
Пам'ятайте: сказ - це смертельне захворювання, але його можна запобігти за допомогою антирабічної вакцинації.
Щоб уберегти себе та своїх близьких від покусів тваринами, рекомендується:
- Не провокувати тварин, не підходити до них занадто близько, не намагатися їх гладити чи годувати.
- Не залишати маленьких дітей без нагляду на вулиці.
- Уникати місць скупчення безпритульних тварин.
- У разі укусу тварини негайно звернутися за медичною допомогою.
-